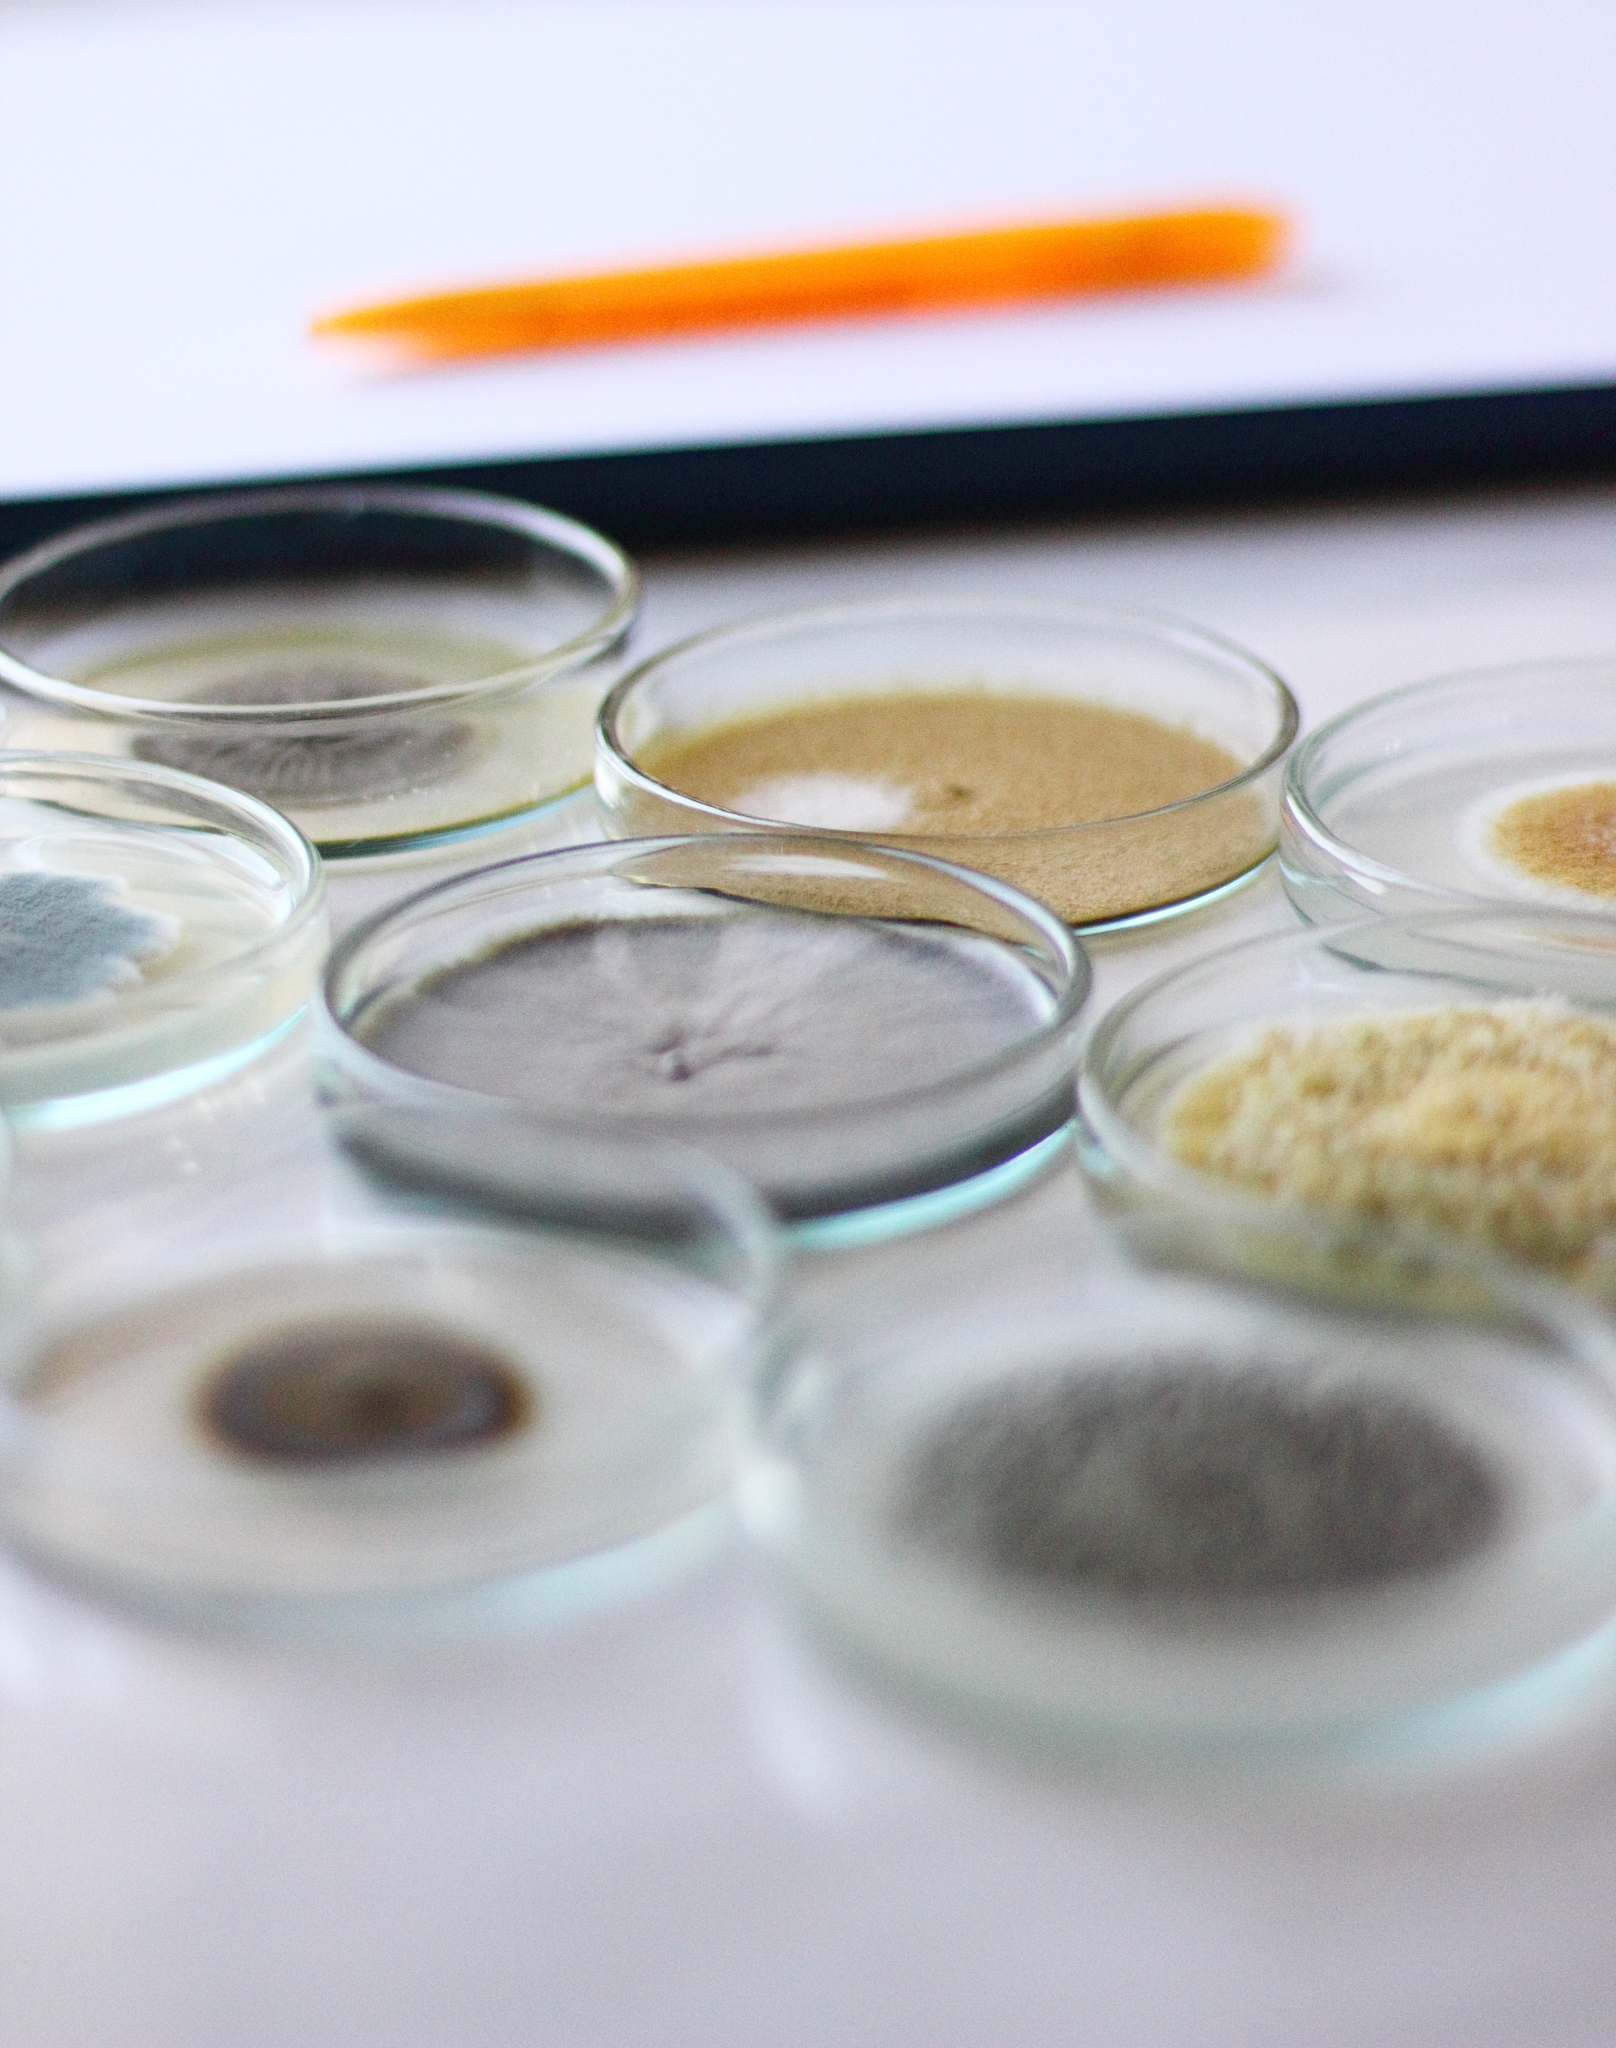
石蜡切片法脱水后是否可以浸泡在石蜡油中？

石蜡切片法脱水后是否可以浸泡在石蜡油中?
是的,石蜡切片法脱水后可以放入石蜡油中浸泡。这样做可以帮助保护样本并提高切片质量。在浸泡前,需要将样本逐渐置于石蜡油中,以避免空气被困在样本中。此外,也需要注意浸泡时间和温度,以确保样本完全浸泡且不会受到过度热力损伤。

原文地址: https://www.cveoy.top/t/topic/mBV2 著作权归作者所有。请勿转载和采集!
安全问答是一个知识全球问答,包含丰富的问答知识
是的,石蜡切片法脱水后可以放入石蜡油中浸泡。这样做可以帮助保护样本并提高切片质量。在浸泡前,需要将样本逐渐置于石蜡油中,以避免空气被困在样本中。此外,也需要注意浸泡时间和温度,以确保样本完全浸泡且不会受到过度热力损伤。
原文地址: https://www.cveoy.top/t/topic/mBV2 著作权归作者所有。请勿转载和采集!